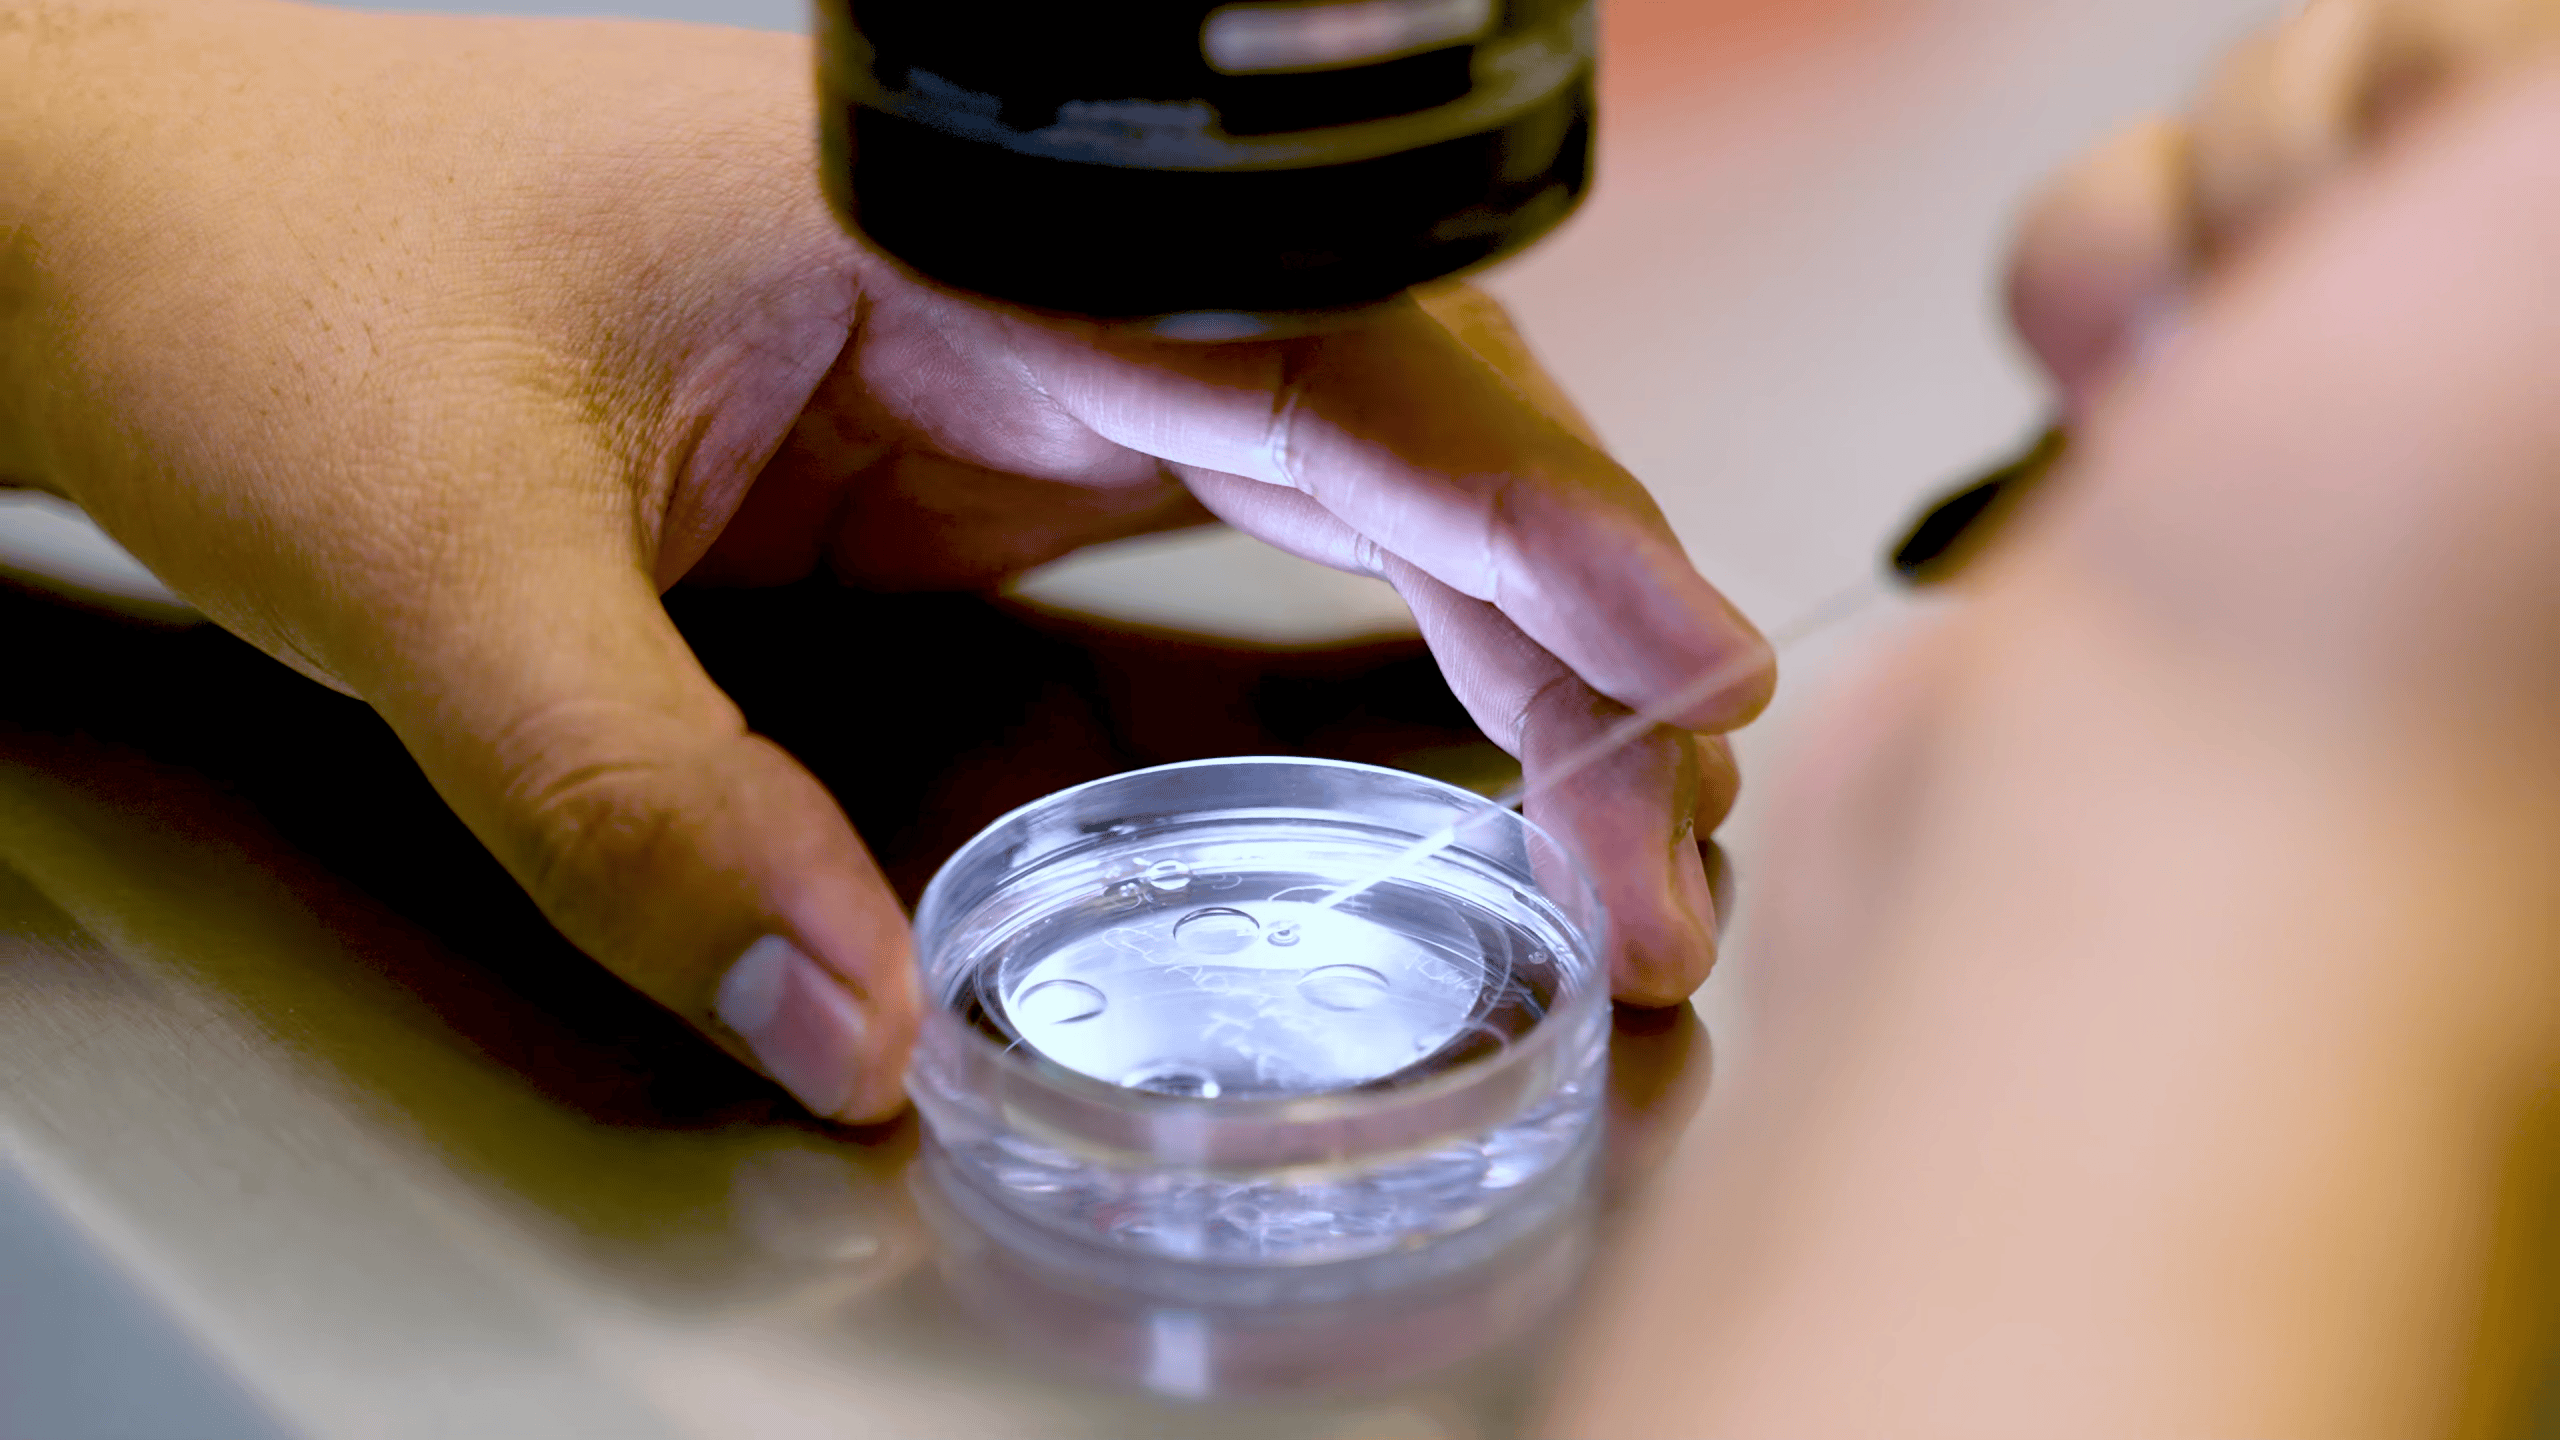
conacyt-and-fertility-investigation-at–Ingenes-Institute-embryologist-analyzing-embryos-in-microscope-within-assisted-reproduction-laboratory

At our artificial insemination center, we provide personalized care to meet the unique needs of each patient. This treatment is ideal for those who want a simpler alternative to more complex fertility procedures. Our artificial insemination center offers services in both the USA and Mexico, ensuring access to top-quality care.
Artificial insemination can help you achieve your dream of having a child. Artificial insemination treatment is designed to give you the best possible chance at success.
It is an Assisted Reproduction procedure of low complexity, which consists of placing sperm into the uterus through a catheter. It’s a less invasive method than high complexity treatments and can increase the chances of fertilization.
The sperm sample can be provided by a partner or from a donor, giving single women, heterosexual couples, and same-sex couples the possibility of having a baby. At our artificial insemination center, we take great care when preparing the sperm sample to maximize its effectiveness in achieving pregnancy. The entire process is quick and has minimal discomfort. It is often one of the first steps taken when addressing fertility issues.
Artificial insemination, USA and Mexico, is widely available and an affordable option for those looking to start or grow their family. It is a safe and proven technique. Many couples find success with just a few cycles. This method is often recommended for those with mild fertility challenges or unexplained infertility.